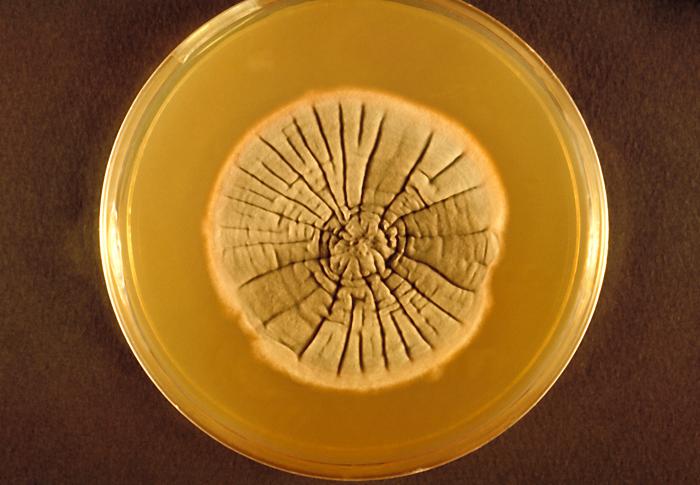

Neotestudina rosatii es un hongo filamentoso que pertenecen al filo Ascomycota.
Macroscópicamente forma colonias de crecimiento lento, color gris pardusco, más o menos aplanadas y con pliegues arrugados. El reverso al principio es de color marrón rosado y después marrón oscuro.
Microscópicamente presenta cleistotecios de color negro, de 200-900 micras (μm) de diámetro y una estructura pseudo-parenquimal con ascos globosos que contienen 8 ascosporas bicelulares, marrones y ligeramente arqueadas (6).
Viabilidad, propagación y transmisión
Reservorio
Suelo y vegetación (cactus o plantas espinosas y astillas de madera).
Hospedadores
Humanos.
Dosis Infectiva Mínima (DIM)
Se desconoce en la actualidad.
Supervivencia ambiental
Es un hongo saprófito, se encuentra en el suelo y en la vegetación, principalmente de áreas tropicales y subtropicales que tienen una corta estación lluviosa y una larga estación seca.
Formas de resistencia
No presenta formas de resistencia.
Mecanismo de propagación y transmisión
La transmisión se produce principalmente por la inoculación de las esporas del hongo en el tejido subcutáneo, mediante pinchazos o arañazos con objetos contaminados como: espinas, astillas, herramientas, etc.
La mayor transmisión se produce en trabajadores del campo (trabajadores agrarios), normalmente hombres de 20 a 40 años, por andar descalzos, sobre todo en países en desarrollo y zonas rurales.
No se transmite de persona a persona (1).
Vías de entrada
Parenteral.
Distribución geográfica
Zonas tropicales y subtropicales como África del este (Somalia, Senegal) y Australia.
Efectos sobre la salud
Grupo de riesgo
2
(Ver Anexo II RD 664/1997 )Infección
Micetoma (eumicetoma), micetoma blanco-amarillento, pie de madura o maduromicosis: es una infección crónica, profunda, de progresión lenta, sin dolor y destructiva de la piel, el tejido subcutáneo, el músculo y el hueso. Normalmente afecta a los pies, pero puede afectar a cualquier parte del cuerpo, principalmente a las extremidades, la región glútea, la espalda, el tronco, la cabeza, el cuello, la cara e incluso la conjuntiva. La lesión inicial es un nódulo eritematoso, indoloro, que crece y se fistuliza drenando material serosanguinolento (pus) y granos blancos o blancoamarillentos (colonias del hongo). Con el tiempo y sin tratamiento la lesión se extiende hacia las zonas profundas como el músculo y el hueso subyacente, produciendo lesiones osteolíticas llamadas geodos y la deformidad y pérdida de función del tejido afectado.
Efectos alérgicos (Ver Anexo II RD 664/1997 ) / (Ver Allergen )
No se han descrito
Efectos tóxicos (Ver Anexo II RD 664/1997 )
No se han descrito
Efectos cancerígenos (Ver International Agency for Research On Cancer - IARC )
No se han descrito
Efectos en la maternidad
No se han descrito
Enfermedad
| CIE-10 | Nombre | Enfermedad de Declaración Obligatoria |
|---|---|---|
| B47 | Micetoma | No |
Actividades laborales con riesgo
Clasificación Nacional de Actividades Económicas (CNAE)
| CNAE 2009 | Descripción |
|---|---|
| A0111 | Cultivo de cereales, distintos de arroz, leguminosas y oleaginosas |
| A0112 | Cultivo de arroz |
| A0113 | Cultivo de hortalizas, raíces y tubérculos |
| A0114 | Cultivo de caña de azúcar |
| A0115 | Cultivo de tabaco |
| A0116 | Cultivo de plantas para fibras textiles |
| A0119 | Otros cultivos no perennes |
| A0121 | Cultivo de la vid |
| A0122 | Cultivo de frutos tropicales y subtropicales |
| A0123 | Cultivo de cítricos |
| A0124 | Cultivo de frutos con hueso y pepitas |
| A0125 | Cultivo de otros árboles y arbustos frutales y frutos secos |
| A0126 | Cultivo de frutos oleaginosos |
| A0127 | Cultivo de plantas para bebidas |
| A0128 | Cultivo de especias, plantas aromáticas, medicinales y farmacéuticas |
| A0129 | Otros cultivos perennes |
| A0130 | Propagación de plantas |
| A0150 | Producción agrícola combinada con la producción ganadera |
| A0161 | Actividades de apoyo a la agricultura |
| A0163 | Actividades de preparación posterior a la cosecha y tratamiento de semillas para reproducción |
| A0210 | Silvicultura y otras actividades forestales |
| A0220 | Explotación de la madera |
| B0510 | Extracción de antracita y hulla |
| B0520 | Extracción de lignito |
| B0710 | Extracción de minerales de hierro |
| B0721 | Extracción de minerales de uranio y torio |
| B0729 | Extracción de otros minerales metálicos no férreos |
| B0812 | Extracción de gravas y arenas y extracción de arcilla y caolín |
| B0892 | Extracción de turba |
| B0899 | Otras industrias extractivas n.c.o.p. |
| B0990 | Actividades de apoyo a otras industrias extractivas |
| E3600 | Captación, depuración y distribución de agua |
| E3700 | Recogida y tratamiento de aguas residuales |
| F4312 | Preparación de terrenos |
| F4313 | Perforaciones y sondeos |
| N7210 | Investigación y desarrollo experimental en ciencias naturales y técnicas |
| O8130 | Actividades de jardinería |
| R8699 | Otras actividades sanitarias n.c.o.p. |
| S9141 | Actividades de los jardines botánicos y los parques zoológicos |
| T9630 | Pompas fúnebres y actividades relacionadas |
Clasificación Nacional de Ocupaciones (CNO)
| CNO 2011 | Descripción |
|---|---|
| 2414 | Geólogos y geofísicos |
| 2421 | Biólogos, botánicos, zoólogos y afines |
| 2821 | Sociólogos, geógrafos, antropólogos, arqueólogos y afines |
| 3122 | Técnicos en construcción |
| 3128 | Técnicos en metalurgia y minas |
| 3132 | Técnicos en instalaciones de tratamiento de residuos, de aguas y otros operadores en plantas similares |
| 3141 | Técnicos en ciencias biológicas (excepto en áreas sanitarias) |
| 3142 | Técnicos agropecuarios |
| 3143 | Técnicos forestales y del medio natural |
| 3313 | Técnicos en anatomía patológica y citología |
| 3314 | Técnicos en laboratorio de diagnóstico clínico |
| 5892 | Empleados de pompas fúnebres y embalsamadores |
| 6110 | Trabajadores cualificados en actividades agrícolas (excepto en huertas, invernaderos, viveros y jardines) |
| 6120 | Trabajadores cualificados en huertas, invernaderos, viveros y jardines |
| 6410 | Trabajadores cualificados en actividades forestales y del medio natural |
| 7223 | Instaladores de conductos en obra pública |
| 8111 | Mineros y otros operadores en instalaciones mineras |
| 8112 | Operadores en instalaciones para la preparación de minerales y rocas |
| 8113 | Sondistas y trabajadores afines |
| 9511 | Peones agrícolas (excepto en huertas, invernaderos, viveros y jardines) |
| 9512 | Peones agrícolas en huertas, invernaderos, viveros y jardines |
| 9530 | Peones agropecuarios |
| 9543 | Peones forestales y de la caza |
| 9601 | Peones de obras públicas |
| 9602 | Peones de la construcción de edificios |
| 9603 | Peones de la minería, canteras y otras industrias extractivas |
Prevención y control
Desinfectantes
No se dispone de información específica para Neotestudina rosatii, pero la mayoría de los hongos son sensibles a hipoclorito sódico, yodóforos, alcoholes, glutaraldehído y peróxido de hidrógeno.
Inactivación física
No se dispone de información específica para Neotestudina rosatii, pero la mayoría de los hongos se inactivan con calor húmedo a 121 ºC durante al menos 15 minutos.
Antimicrobianos
Itraconazol, ketoconazol.
Vacunación
No disponible
Medidas preventivas generales
Disponer de ventilación adecuada en los lugares de trabajo, evitar la humedad rela-tiva alta y condensaciones, además de implantar un programa periódico de limpieza y mantenimiento de locales, instalaciones y equipos.
Reducir el uso de herramientas cortantes o punzantes, en caso necesario, utilizarlas con las debidas precauciones y protecciones.
Evitar procesos pulvígenos o que generen bioaerosoles; si no es posible, cerramiento o aislamiento de dichos procesos, o disponer de un sistema de extracción localizada.
Higiene personal, mantener la piel limpia y seca, lavado de manos después de tocar materiales o elementos potencialmente contaminados. Utilizar ropa de trabajo y equipos de protección individual, sobre todo calzado y guantes, en la medida de lo posible, resistentes a la perforación.
Limpieza y desinfección de cortes, arañazos o heridas en la piel, evitar el contacto de las mismas con elementos contaminados. Cubrir las heridas con apósitos estériles e impermeables.
Precauciones en centros sanitarios
En hospitales y centros sanitarios, adoptar las Precauciones Estándar (8).
EPI
Protección de las manos: guantes de protección frente a microorganismos y de cierta resistencia mecánica en caso de contacto o manipulación de materiales potencialmente infecciosos.
Calzado de trabajo de resistencia mecánica a la perforación.
Protección ocular o facial: gafa de protección de montura universal en caso de riesgo de contacto accidental mano/guante contaminado-ojo, o pantalla de protección facial (símbolo de marcado en montura: 3) en caso de riesgo de exposición a salpicaduras, o gafa de protección de montura integral con hermeticidad frente a partículas (símbolo de marcado en montura: 4), en caso de riesgo de exposición a polvo.
Seguridad en laboratorio
Nivel de contención: 2
El principal riesgo es la inoculación accidental y el contacto del hongo con la piel o mucosas lesionadas.
Las muestras más peligrosas son muestras ambientales contaminadas (suelo, vegetales, madera) y cultivos del hongo.
Se requieren las prácticas y las medidas de contención de un nivel 2 de bioseguridad, evitar el empleo de material cortante o punzante, utilizar cabina de seguridad biológica en aquellas operaciones que impliquen la generación de bioaerosoles, proyecciones o salpicaduras y utilizar guantes frente a microorganismos en el caso de contacto con muestras contaminadas, y bata o ropa de trabajo.
Bibliografía
- López-Vélez, R., Martín, E., & Pérez, J. A. (2008). Guía de enfermedades infecciosas importadas. Ministerio de Sanidad y Consumo.
- Rubio, M. C., Gil, J., Benito, T. R., Ramírez de Ocáriz, I., & Navarro, M. (2007). Micosis más frecuentes en nuestro medio. En Guía práctica de identificación y diagnóstico en micología clínica (2ª ed.) (Capítulo 2). Revista Iberoamericana de Micología.
- Sánchez-Saldaña, L., Galarza, C., & Matos-Sánchez, R. (2009). Infecciones micóticas subcutáneas. Dermatología peruana, 9(4), 362-387.
- Centers for Disease Control and Prevention (CDC). (2020). Biosafety in microbiological and biomedical laboratories (6th ed.).
- Centers for Disease Control and Prevention (CDC). (2020). Mycetoma. CDC: Fungal diseases.
- Institut National de Recherche et de Sécurité (INRS). (2023). Neotestudina rosatii. BAse d'OBservation des Agents Biologiques (BAOBAB).
- Instituto Nacional de Seguridad e Higiene en el Trabajo (INSHT). (2014). Guía técnica para la evaluación y prevención de los riesgos relacionados con la exposición a agentes biológicos (2ª ed.).
- Servicio Riojano de Salud. (2008). Precauciones de aislamiento en centros sanitarios.
- World Health Organization (WHO). Mycetoma, chromoblastomycosis and other deep mycoses.